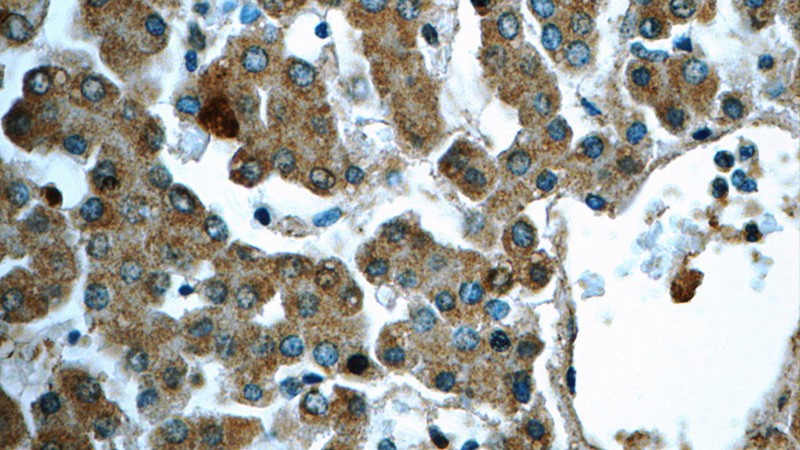
Immunohistochemistry of paraffin-embedded human liver tissue slide using Catalog No:111453(HPS4 Antibody) at dilution of 1:50

-
Product Name
HPS4 antibody
- Documents
-
Description
HPS4 Rabbit Polyclonal antibody. Positive IHC detected in human liver tissue. Positive IF detected in HepG2 cells. Positive IP detected in Hela cells. Positive WB detected in A375 cells, HeLa cells, K-562 cells. Observed molecular weight by Western-blot: 70 kDa and 90 kDa
-
Tested applications
ELISA, WB, IF, IP, IHC
-
Species reactivity
Human; other species not tested.
-
Alternative names
bK1048E9.4 antibody; bK1048E9.5 antibody; Hermansky Pudlak syndrome 4 antibody; HPS4 antibody; KIAA1667 antibody; Light ear protein homolog antibody
-
Isotype
Rabbit IgG
-
Preparation
This antibody was obtained by immunization of HPS4 recombinant protein (Accession Number: XM_017029044). Purification method: Antigen affinity purified.
-
Clonality
Polyclonal
-
Formulation
PBS with 0.1% sodium azide and 50% glycerol pH 7.3.
-
Storage instructions
Store at -20℃. DO NOT ALIQUOT
-
Applications
Recommended Dilution:
WB: 1:200-1:1000
IP: 1:200-1:2000
IHC: 1:20-1:200
IF: 1:10-1:100
-
Validations

A375 cells were subjected to SDS PAGE followed by western blot with Catalog No:111453(HPS4 antibody) at dilution of 1:200

IP result of anti-HPS4 (Catalog No:111959 for IP and Detection) with HeLa cell lysate.

Immunofluorescent analysis of HepG2 cells, using HPS4 antibody Catalog No:111453 at 1:25 dilution and Rhodamine-labeled goat anti-rabbit IgG (red). Blue pseudocolor = DAPI (fluorescent DNA dye).
Immunohistochemistry of paraffin-embedded human liver tissue slide using Catalog No:111453(HPS4 Antibody) at dilution of 1:50
-
Background
Hermansky-Pudlak syndrome (HPS) is a genetic disease characterized by oculocutaneous albinism, bleeding due to platelet storage pool deficiency, and lysosomal storage defects. This syndrome results from defects of diverse cytoplasmic organelles including melanosomes, platelet dense granules and lysosomes. HPS1 and HPS4 are the most frequently mutated genes associated with HPS in humans. Both of HPS1 and HPS4 are components of two complexes involved in biogenesis of melanosome and lysosome-related organelles: BLoc-3 and BLoc-4. HPS4 is supposed to interact with HPS1 and stabilize HPS1. The human HPS4 migrates at about 90 kDa on SDS-PAGE, versus its predicated molecular mass of 77 kDa.
-
References
- Ikawa Y, Hess R, Dorward H. In vitro functional correction of Hermansky-Pudlak Syndrome type-1 by lentiviral-mediated gene transfer. Molecular genetics and metabolism. 114(1):62-5. 2015.
Related Products / Services
Please note: All products are "FOR RESEARCH USE ONLY AND ARE NOT INTENDED FOR DIAGNOSTIC OR THERAPEUTIC USE"
